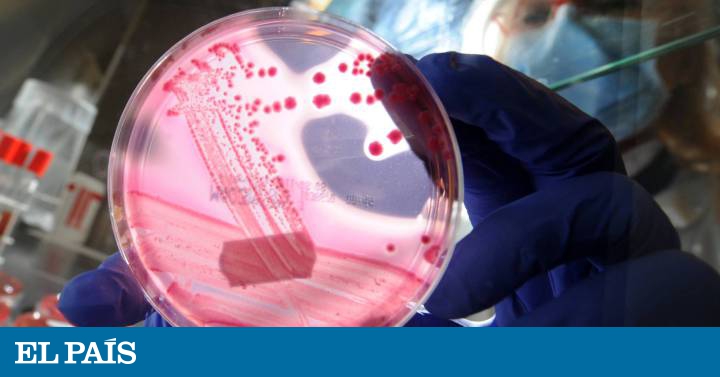

Busco microbioma en Bing y me salen vídeos italianos, por alguna razón. Philippe Langella nos ilustra sobre el microbioma intestinal de los “sujetos ancianos”, mientras Luca Masucci diserta acerca de la seguridad de los trasplantes de heces. “Microbioma y medicina veterinaria”, añade Antonio Gasbarrini sin reparar en que Franco Vicariotto ya había dado un pelotazo histórico con su vídeo “microbioma y la mujer”. La búsqueda en Google mejora un poco las cosas, pero no demasiado. Otras webs de Muy interesante, Efe Salud y el Instituto Roche nos terminan de sembrar en el hipocampo el virus cerebral (meme, en la nomenclatura de Richard Dawkins) de que el microbioma, la colección de mil especies de bacterias, virus y hongos que llevamos en el intestino y otras partes blandas, es la causa de todos los males y por tanto la solución a todos ellos. La presión de la industria alimentaria es fuerte y los sabiondos proliferan como setas de cardo en nuestra sociedad crédula e intoxicada por las redes. Mal asunto.
Y mira que la investigación del microbioma es bien activa e interesante. Los científicos dedicados a ello aspiran a descubrir si existe un microbioma saludable y cómo estimular su composición de bacterias en las personas que no tienen la suerte de llevarlo puesto de nacimiento en las tripas. Gracias a eso sabemos que el cáncer, el autismo y las enfermedades autoinmunes, que van desde la esclerosis múltiple hasta la artritis reumatoide, tienen relación con el microbioma. ¿No sería fantástico que pudiéramos tratar esas afecciones sin más que modificar la dieta? Sin duda. Sería fantástico, pero en sentido literal, porque no estamos aún en condiciones de recomendar una dieta que estimule un microbioma saludable. No hagas caso a los chamanes. Lo peor no es que quieran robarte la cartera. Lo peor es que no tienen ni idea de lo que hablan.
Peter Turnbaugh, microbiólogo de la Universidad de California en San Francisco, es uno de los responsables de la mala fama que han adquirido las carnes rojas y procesadas. Los resultados de su laboratorio indican que, en ratones, comer carne reduce las bacterias que metabolizan la fibra y promueve la enfermedad inflamatoria intestinal. Pero él mismo reconoce que sus estudios son insuficientes y extremos en las dosis de carne que consumen los animales. “¿Refleja eso lo que ocurre en la gente que sigue unas dietas más típicas?”, se pregunta. La respuesta es que no lo sabemos. Turnbaugh piensa que estos datos son valiosos para los científicos y que algún día pueden conducir a un remedio farmacológico. Pero no estamos ni de lejos en condiciones de recomendar ninguna dieta que mejore el microbioma de la población.
Hay otro asunto que merece la pena comentar. El mes pasado, Nature publicó una colección de artículos sobre el microbioma y sus efectos en la salud humana. El trabajo fue financiado por Danone y, de hecho, Patrick Veiga, Silvia Miret y Liliana Jiménez, de Danone Nutricia Research en Palaiseau, Francia, colaron en el paquete un artículo titulado “Danone: el microbioma y la probiótica, 100 años de historia compartida”. Los editores de Nature se han visto compelidos a aclarar: “Nos complace reconocer el apoyo financiero de Danone; como siempre, Nature es la única responsable de todo el contenido editorial”. Como siempre.
Puedes seguir EL PAÍS Opinión en Facebook, Twitter o suscribirte aquí a la Newsletter.